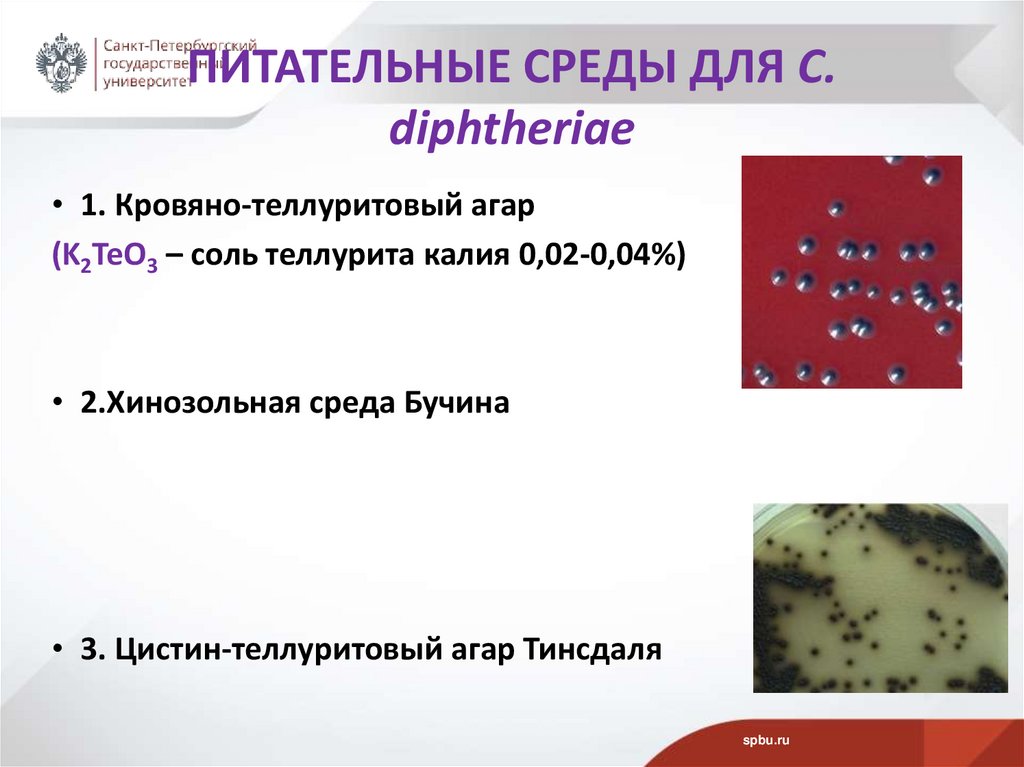
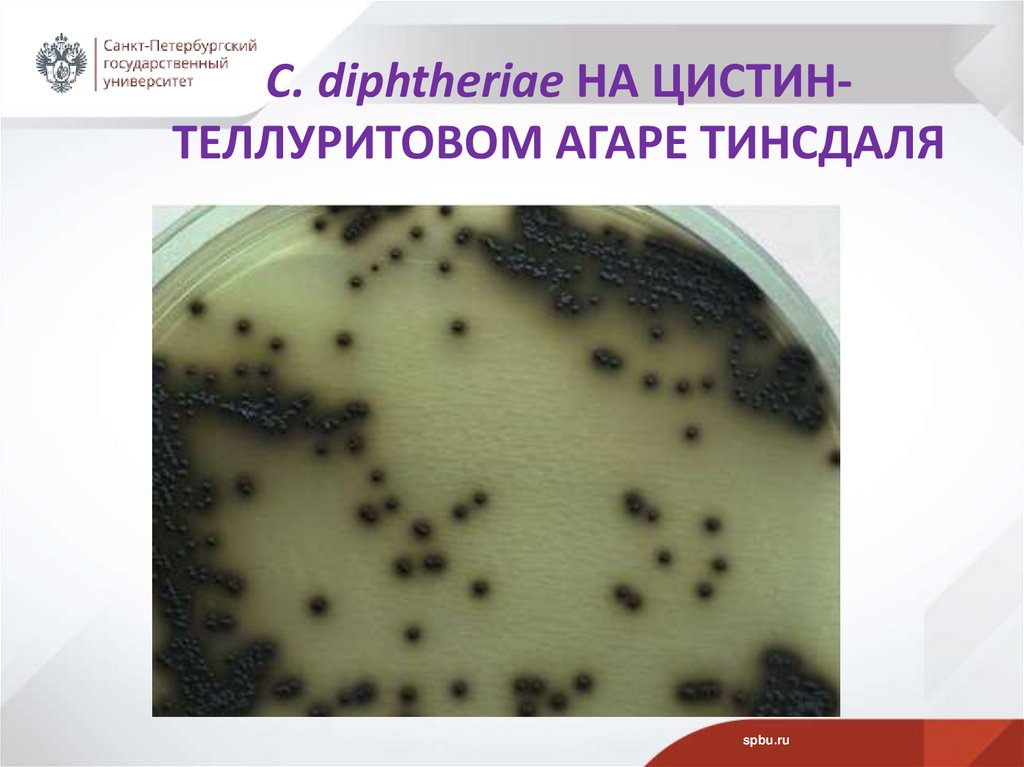
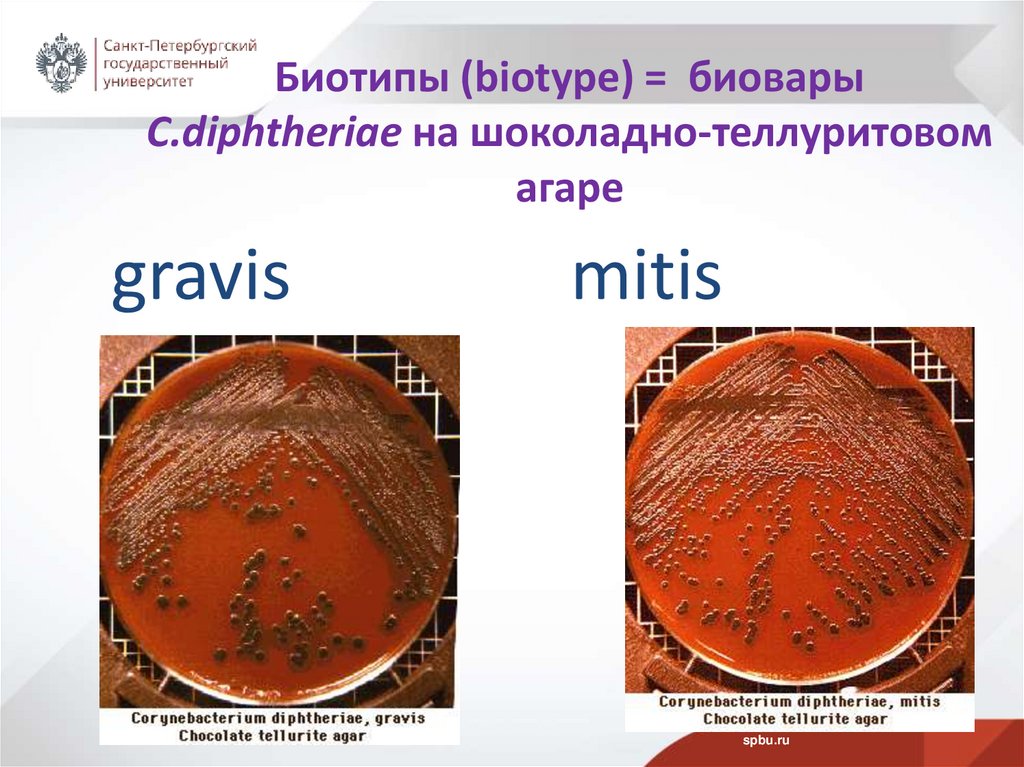
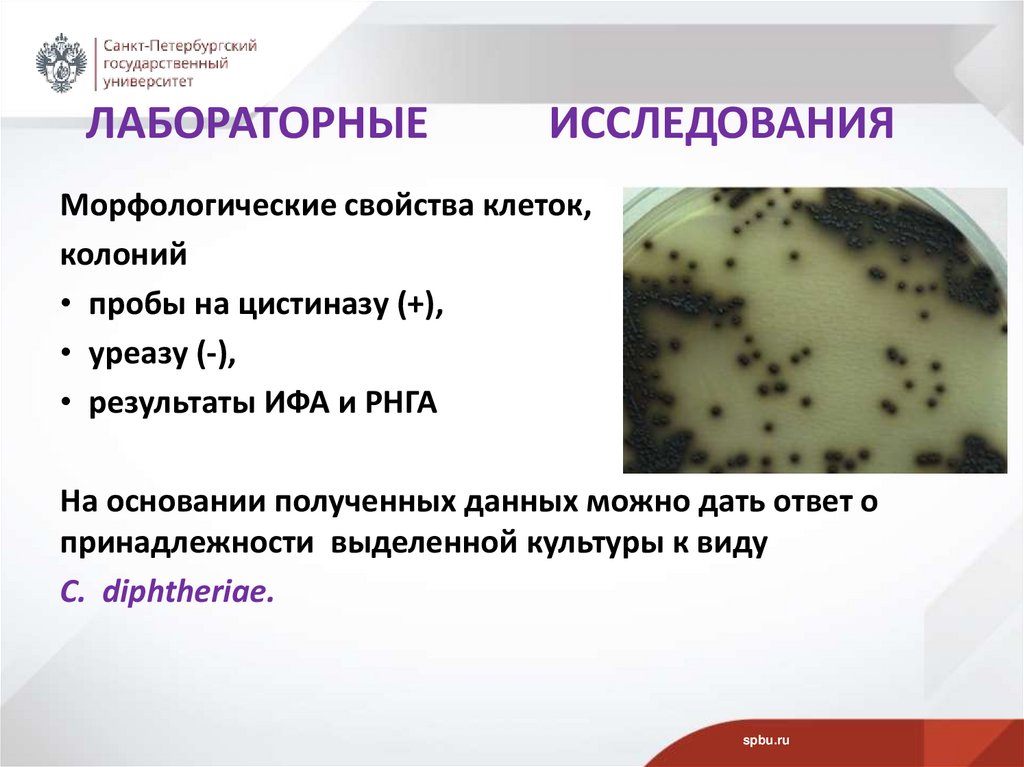

Similar presentations:
Возбудитель дифтерии (Corynebacterium diphtheriae)
1. ВОЗБУДИТЕЛЬ ДИФТЕРИИ Corynebacterium diphtheriae
Д.б.н., проф.Рыбальченко О.В.
СПбГУ
06.03.2025
2. ПЛАН ЛЕКЦИИ
• 1. Дифтерия. История открытия.• 2. Пути передачи инфекции.Контакт с токсигенными и
атоксигенными штаммами C. diphtheriae. Очаги поражения.
• 3. Причины возникновения эпидемии дифтерии.
Необходимость вакцинации и ревакцинации.
• 4. Таксономия и общая характеристика рода Corynebacterium.
• 5. Морфологические, биохимические свойства, АГ структура.
• 6. Культуральные свойства. Биотипы.
• 7. Дифтерийный токсин -основной фактор патогенности.
• 8. Лабораторная диагностика
• 9. Чувствительность к АМП
• 10. Специфическая профилактика, проба Шика.
spbu.ru
3. Вопрос 1 ДИФТЕРИЯ (от греч. diphtheria – кожа, пленка)
• Дифтерия – антропонозное инфекционное заболевание,характеризующееся синдромом общей интоксикации с
преимущественным поражением сердечно-сосудистой и
кортико-адреналовой систем, периферических нервов, а
также развитием фибринозного воспаления во входных
воротах инфекции.
spbu.ru
4. ФИБРИНОЗНОЕ ВОСПАЛЕНИЕ (ФВ)
• ФВ - различные этиологические причины:- возбудители дифтерии и дизентерии,
- стрептококки и стафилококки,
- микобактерии туберкулеза,
- вирусы гриппа и т.д.
ФВ локализуется на слизистых и
серозных оболочках, в легких.
При ФВ: происходит образование экссудата содержит фибриноген, в пораженной ткани превращается в
фибрин.
spbu.ru
5. ИСТОРИЯ ОТКРЫТИЯ ВОЗБУДИТЕЛЯ ДИФТЕРИИ
1883 г. - открыты C. diphtheriae Э. Клебсомв дифтерийных пленках.
В 1884 г. - Ф. Леффлер выделил чистую культуру.
В 1888 г. - Э. Ру и А. Йерсен получили дифтерийный токсин.
1895 г. – Э. Беринг и Э. Ру независимо друг от друга
получили противодифтерийную сыворотку, которую
впервые для лечения дифтерии применил в 1897 г. П.
Эрлих.
В 1894 г. - в России Г.Н. Габричевский применил
противодифтерийную сыворотку с лечебной целью и
организовал ее производство.
spbu.ru
6. Вопрос 2 ПУТИ ПЕРЕДАЧИ ИНФЕКЦИИ ПРИ ДИФТЕРИИ
• Воздушно-капельный• Контактный (предметы быта)
• На месте внедрения возбудителя –
воспалительный процесс
spbu.ru
7. КОНТАКТ ЧЕЛОВЕКА С КЛЕТКАМИ C.diphtheriae
• При контакте может возникнуть 3 состояния:1. Носительство
2. Субтоксическая форма заболевания (легкая)атоксигенные C. diphtheriae - назофарингит и эндокардит.
3. Токсическая форма заболевания (тяжелая) -токсигенные
C. diphtheriae - дифтерию.
spbu.ru
8. ОЧАГИ ПОРАЖЕНИЯ ПРИ ДИФТЕРИИ
В зависимости от локализации различают дифтерию:зева, носа, гортани, глаза, уха, половых органов, кожи,
ран.
spbu.ru
9. КЛИНИЧЕСКИЕ ПРОЯВЛЕНИЯ ДИФТЕРИИ
Дифтерия глазаspbu.ru
10. ДИФТЕРИЯ КОЖИ
spbu.ru11. ДИФТЕРИЯ ГОРТАНИ
spbu.ru12. Вопрос 3 ПРИЧИНЫ ВОЗНИКНОВЕНИЯ ЭПИДЕМИИ ДИФТЕРИИ в конце ХХ в.
В конце 50-х гг. – наблюдали временное благополучие врезультате активной вакцинации.
1994 г. - пик эпидемии.
РФ - 29,9 /100 тыс. населения
СПб – 52,7/100 тыс. населения)
Причины развития эпидемии:
Утрата прослойки иммунизированных со специфическим
антитоксическим иммунитетом.
Сомнительное качество вакцины и нарушение технологии
проведения прививок.
Распространение заболевания в результате бесконтрольной
миграции населения.
spbu.ru
13. НЕОБХОДИМОСТЬ ВАКЦИНАЦИИ И РЕВАКЦИНАЦИИ ОТ ДИФТЕРИИ
Среди невакцинированных:• Субтоксическая форма заболевания - 41%
• Токсическая форма заболевания - 74%
• ПРИВИВАТЬ НАДО!!!
spbu.ru
14. Вопрос 4 ТАКСОНОМИЯ РОДА Corynebacterium 2020 г.
Род Corynebacterium – 147 видов.Наиболее значимы:
C. diphtheriae - типовой вид,
C. ulcerans – мастит КРС, человек,
C. pseudotuberculosis – абсцессы у животных и человека,
C. striatum – нормальная микробиота ротовой полости
человека, глотка, зубные бляшки, мастит КРС,
C. minutissimum – комменсалы человека,
C. xerosis – нормальная микробиота слезного канала,
человека, эндокардит, пневмония, конъюнктивит,
C. pseudodiphtheriticum (палочка Хофманна) –
непатогенный вид.
spbu.ru
15. ОБЩАЯ ХАРАКТЕРИСТИКА РОДА Corynebacterium
Гр+ палочкинеподвижные, бесспоровые факультативные анаэробы,
каталаза+
особое химическое строение клеточной стенки: короткие
цепи (22-36 атомов С) миколовых кислот и
мезо-диаминопимелиновая кислота.
spbu.ru
16. Вопрос 5. МОРФОЛОГИЧЕСКИЕ СВОЙСТВА КЛЕТОК C. diphtheriae
• Гр(+) полиморфные палочки (ветвистые, раздутые),длина 1 - 8 мкм.
• Нет капсулы, спор и жгутиков
• Характерное расположение клеток в мазках в виде
китайских иероглифов (X, V, Y)
spbu.ru
17. ХАРАКТЕРИСТИКА КЛЕТОК C. diphtheriae
spbu.ru18. ВОЛЮТИНОВЫЕ ЗЕРНА В КЛЕТКАХ C. diphtheriae
Окраскаметиленовым синим
Рисунок волютиновых
зерен в клетках
spbu.ru
19. БИОХИМИЧЕСКИЕ СВОЙСТВА C. diphtheriae
1.редукция нитратов (+)2. цистиназная активность (+) (проба Пизу),
3. уреазная активность (-) (проба Закса),
4. ферментация углеводов:
глюкоза (+), сахароза (-), крахмал (+).
spbu.ru
20. АГ СТРУКТУРА C. diphtheriae
• На основании строения О-АГ и К-АГ различают 11сероваров
• Повышенная склонность к спонтанной агглютинации!!!
spbu.ru
21. Вопрос 6. КУЛЬТУРАЛЬНЫЕ СВОЙСТВА C. diphtheriae
• Факультативные анаэробы - O/F тест +/+.• Не выносят низкой температуры – транспортировать
нужно с подогревом!!!
• Опт. температура 37˚С, рН 7,4-8,0.
• Нуждается в 150-180 мг % аминного азота. Требуется
добавка нативного белка около 10-15%
дефибринированной крови.
• Долго сохраняются в высушенном состоянии (слюна,
пыль).
• Дез. средства 3-5% - гибель через 20-30 мин.
• В ЖПС при 60˚С гибель за 10 мин.
spbu.ru
22. ПИТАТЕЛЬНЫЕ СРЕДЫ ДЛЯ C. diphtheriae
• 1. Кровяно-теллуритовый агар(K2TeO3 – соль теллурита калия 0,02-0,04%)
• 2.Хинозольная среда Бучина
• 3. Цистин-теллуритовый агар Тинсдаля
spbu.ru
23. КОЛОНИИ C. diphtheriae НА КРОВЯНО-ТЕЛЛУРИТОВОМ АГАРЕ
КОЛОНИИ C. diphtheriae НА КРОВЯНОТЕЛЛУРИТОВОМ АГАРЕspbu.ru
24. C. diphtheriae НА ЦИСТИН-ТЕЛЛУРИТОВОМ АГАРЕ ТИНСДАЛЯ
C. diphtheriae НА ЦИСТИНТЕЛЛУРИТОВОМ АГАРЕ ТИНСДАЛЯspbu.ru
25. БИОТИПЫ C. diphtheriae НА КРОВЯНО-ТЕЛЛУРИТОВОМ АГАРЕ
gravis -крупные, серые, сухие, крошащиеся, шероховатые срадиальной исчерченностью колонии. Через 24 ч клетки –
короткие, полиморфные палочки, с небольшим количеством
волютина. Ферментируют крахмал. Вызывают заболевание в
крайне тяжелой форме.
mitis- черные, круглые, выпуклые колонии. В препаратах длинные
изогнутые палочки с большим количеством волютина. Не
ферментируют крахмал. Вызывают заболевание в легкой форме.
spbu.ru
26. Биотипы (biotype) = биовары C.diphtheriae на шоколадно-теллуритовом агаре
gravismitis
spbu.ru
27. ХИНОЗОЛЬНАЯ СРЕДА БУЧИНА
spbu.ru28. Вопрос 7. ДИФТЕРИЙНЫЙ ЭКЗОТОКСИН
• Генетическая информация (ген tox+) о продуцированииэкзотоксина клетками C. diphtheriae закодирована в
геноме умеренного бактериофага.
• Всего у C. diphtheriae - 11 умеренных фагов,
• из них 5 фагов содержат ген tox+ «молчащие» гены?
Умеренный бактериофаг C. diphtheriae (ТЭМ)
spbu.ru
29. ТОКСИГЕННЫЕ И АТОКСИГЕННЫЕ ШТАММЫ C. diphtheriae
• Токсигенные C. diphtheriae (ген tox+) - вызываютдифтерию.
• Атоксигенные C. diphtheriae (ген tox-) - вызывают
назофарингит и эндокардит.
spbu.ru
30. ДИФТЕРИЙНЫЙ ЭКЗОТОКСИН ОСНОВНОЙ ФАКТОР ПАТОГЕННОСТИ C. diphtheriae
Цитотоксическое действие на клетки сердца, почек,нервной системы.
Нарушение белоксинтезирующих функций
клеток.
ЭКЗОТОКСИН - Белок ~ 61 кДа
Препятствует включению метионина
в пептидную цепочку.
spbu.ru
31. ДИФТЕРИЙНЫЙ ЭКЗОТОКСИН
Рецептор дифтерийного токсина DT - заякоренный в мембранечеловеческий гепарин-связывающий эпидермальный фактор роста,
подобный фактору роста HB-EGF
spbu.ru
32. МЕХАНИЗМ ОБРАЗОВАНИЯ ПЛЕНОК
Клетки токсигенных штаммов: экзотоксин и ферменты(нейраминидаза), формируют очаг воспаления.
Местное действие DT - коагуляционный некроз эпителия, развитие
гиперемии сосудов и стаза крови в капиллярах, повышение
проницаемости стенок сосудов.
Экссудат (фибриноген, лейкоциты, макрофаги и эритроциты) выходит
за пределы сосудистого русла.
На поверхности слизистой оболочки в результате контакта с
тромбопластином (ФСК III) некротизированной ткани фибриноген
превращается в фибрин.
Сгустки фибрина и некротизированный эпителий – плотное, объемное
образование — дифтерийная пленка.
Пленка приобретает грязноватый цвет и вызывает воспаление кожи на
краях раны.
spbu.ru
33. Вопрос 8. ЛАБОРАТОРНАЯ ДИАГНОСТИКА
Материал для исследования: пленки, слизь с миндалин,зева, носа, кожи, глаз, уха, ран, вагины, с границы здоровой
и пораженной ткани.
Высев на среды:
кровяно-теллуритовый агар,
хинозольную среду Бучина
цистин-теллуритовую среду Тинсдаля.
Выбирают колонии (темно-серые и черные,
1,5-2 мм в диаметре, выпуклые, круглые или шероховатые).
На среде Бучина колонии синего или фиолетового цвета.
Экспресс-метод выявления дифтерийного токсина (реакция
преципитации, ИФА, РНГА)
spbu.ru
34. ЛАБОРАТОРНЫЕ ИССЛЕДОВАНИЯ
Морфологические свойства клеток,колоний
• пробы на цистиназу (+),
• уреазу (-),
• результаты ИФА и РНГА
На основании полученных данных можно дать ответ о
принадлежности выделенной культуры к виду
C. diphtheriae.
spbu.ru
35. Вопрос 9. ЧУВСТВИТЕЛЬНОСТЬ К АМ ПРЕПАРАТАМ
• Пенициллин• Эритромицин
• Хлорамфеникол
• Гентамицин
• Стрептомицин
• Тетрациклин
spbu.ru
36. Экстренное введение противодифтерийной антитоксической сыворотки, не дожидаясь результатов микробиологического анализа
1.Нейтрализациятоксина путем
введения
противодифтерийной
антитоксической
сыворотки
(донорской или
лошадиной)
2. Антибиотикотерапия:
пенициллины,
цефалоспорин, хинолон
и др.
Памятник ездовой собаке Балто, перевозившей
медикаменты во время эпидемии
дифтерии в 1925 г. на Аляске.
spbu.ru
37. Вопрос 10. СПЕЦИФИЧЕСКАЯ ПРОФИЛАКТИКА
Проба Шика (Schick test) - для оценки состояния антитоксическогоиммунитета.
Австрийский педиатр B. Schick (1877–1967) – кожная проба для оценки
восприимчивости человека к дифтерии.
Основана на оценке выраженности местной реакции (покраснение, отек)
через 3–4 суток после внутрикожного введения разведенного активного
дифтерийного токсина.
Проба для выявления детей, подлежащих прививкам против дифтерии.
При наличии АТ против дифтерийного токсина видимых изменений не
будет.
При отсутствии антитоксического имммунитета наблюдается
воспалительная реакция.
spbu.ru
38. СПЕЦИФИЧЕСКАЯ ПРОФИЛАКТИКА АКДС
Вакцина – дифтерийный анатоксин (дифтерийныйгистотоксин, утративший токсичность, но сохранивший
антигенные свойства в результате обработки формалином
при 37-400С в течение 3 недель:
АД – адсорбированный дифтерийный анатоксин.
АДС – адсорбированный дифтерийно-столбнячный
анатоксин.
АДС-М анатоксин-вакцина для профилактики дифтерии и
столбняка с уменьшенным содержанием антигенов.
АД-М анатоксин-вакцина для профилактики дифтерии с
уменьшенным содержанием антигенов.
АКДС – адсорбированная коклюшно-дифтерийностолбнячная вакцина.
spbu.ru
39. СПЕЦИФИЧЕСКАЯ ПРОФИЛАКТИКА
Имовакс Д.Т. Адюльт (Imovax D.T.Adult®) вакцина для профилактикидифтерии и столбняка, аналог АДС-М (Aventis Pasteur, Франция);
ДТ Вакс вакцина для профилактики дифтерии и столбняка, аналог АДС
(Aventis Pasteur, Франция);
ТетрАкт-ХИБ Адсорбированная вакцина против дифтерии, столбняка,
коклюша и гемофильной инфекции типа b (Франция);
Тританрикс вакцина для профилактики коклюша, дифтерии, столбняка
и гепатита В (СмитКляйн Бичем, Бельгия);
Тетракок 05 вакцина для профилактики коклюша, дифтерии, столбняка
и полиомиелита (Aventis Pasteur,Франция);
Инфанрикс - бесклеточная вакцина для профилактики коклюша,
дифтерии и столбняка (Бельгия);
Пентаксим - вакцина для профилактики дифтерии и столбняка
адсорбированная, коклюша ацеллюлярная, полиомиелит и
Haemophilus influenzae тип b конъюгированная(Фр.).
spbu.ru

medicine
medicine








